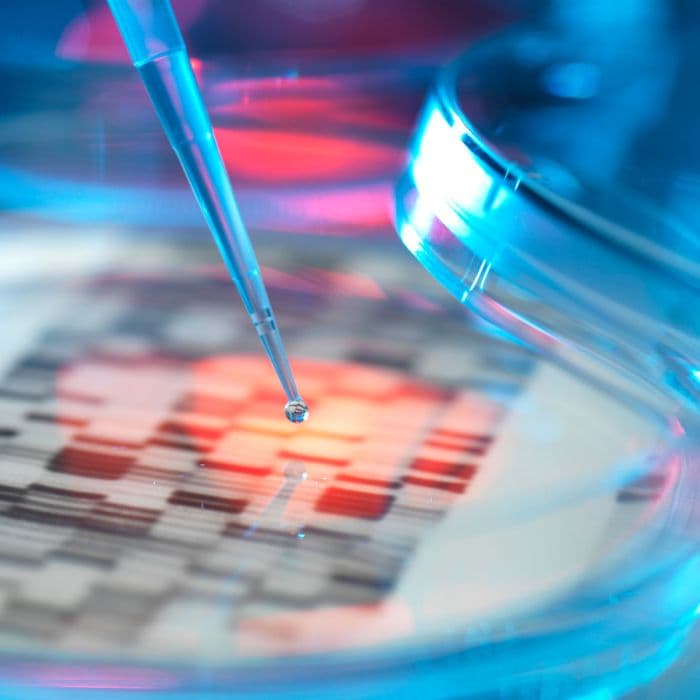
What Costs Are Eligible?

Turn High-Value Projects into Tax Savings with the RIC
The Refundable Investment Credit (RIC) is a government-backed incentive by the Singapore Economic Development Board (EDB) that offers refundable tax credits of 10%, 30%, or 50% on qualifying expenditures. It supports companies making significant new or expanded investments in Singapore’s priority sectors.
KEY HIGHLIGHTS
- Refundable tax credits on qualifying expenditures
- Aligned with Global Minimum Tax (GMT) regulations
- Offsets Corporate Income Tax, including Top-up Taxes
- Unutilised credits refundable in cash within 4 year